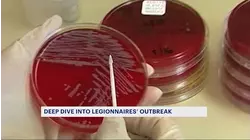
News 12 takes deep dive into deadly 2015 Legionnaires' outbreak in South Bronx following Harlem outbreak

Free movies
Crime FilesThey were a NJ "power couple" but behind the scenes was a different story with a deadly ending.![News 12 New York]()

On now
Up next
Crime FilesThey were a NJ "power couple" but behind the scenes was a different story with a deadly ending.0
Crime FilesA 5-year old Dulce Alavez disappeared from a playground in NJ and her disappearance still remains a mystery.Top Stories
Now Playing2minGinuwine attracting new fans thanks to TikTok: 'It's a blessing'
Now Playing1minPolice: Owner of International Wine Shop in Westport faces charges for selling alcohol to minors
Now Playing2minBill passes aiming at helping New Jersey's bus driver shortage
Now Playing2minHeadlines: Mount Vernon man arrested in kidnap plot, Peekskill shooting incident, New Rochelle stolen car case
Now Playing3minNational Black Business Month: Elevation Dental Studio in Mount Vernon
Now Playing1minPaterson school closing due to safety concerns after ceiling collapse last month
Now Playing1minVideo: Pedestrian narrowly avoids car crash in Garfield
Now Playing1minNurses, patients share outrage in fall closing of Kingsbrook Jewish Medical Center departments
Now Playing3minBreak down negative stereotypes about an endangered species at the Wolf Conservation Center in South Salem
Now Playing2minCity organizations unite to deliver thousands of freshly made meals to Brooklyn residents
Now Playing2minAuthorities: Man shot following police officer hammer attack in Middletown
Now Playing1minThousands gather to mourn loss of Grand Rebbe based in Brooklyn
Now Playing3minUmberto's of New Hyde Park to host car show to benefit Island Harvest
Now Playing1minGuardian Angels Founder, ex-mayoral candidate Curtis Sliwa arrested at migrant relief center rally in Queens
Now Playing1minBacteria found in raw shellfish linked to two Connecticut deaths also blamed for New York death
Now Playing3minNYPD: 9-year-old boy found dead in water after going missing in Red Hook IKEA
Now Playing3minPlainfield continues to help tenants of condemned apartment building as nearly 200 more violations are found
Now Playing1minNonprofit to host back-to-school event offering school supplies for families
Now Playing2minA look back at New Jersey's summer weather in 2023
Now Playing2minWeather to Watch: Pop-up showers possible this afternoon, thunderstorms likely overnight
Now Playing2minHumidity and mostly cloudy skies for Connecticut
Now Playing3minKane In Your Corner: How to protect yourself from online shopping scams
Now Playing3minConcerns rise over frequent false fire alarms at White Plains apartment building
Now Playing1minMember of Bridgeport gang pleads guilty to racketeering offenses
Now Playing3minMostly cloudy skies with sunny breaks today, showers return late tonight
Weather
Now Playing3minSoggy and cool Wednesday ahead of more pleasant weather to end the week
Now Playing4minHurricane Erin steers dangerous conditions toward New Jersey beaches
Now Playing1minSTORM WATCH: Scattered storms, localized flooding possible Wednesday in the Hudson Valley
Now Playing3minRain, storm chances Wednesday in The Bronx; beware of dangerous surf
Now Playing2minRain, storm chances Wednesday in Brooklyn; beware of dangerous surf
Now Playing3minSTORM WATCH: Heavy rainfall possible Wednesday on Long Island; watch for dangerous surf
Now Playing2minSun with highs in the mid-70s today, rain chances increase this week
Now Playing3minFall-feel with highs in the mid-70s, dangerous rip currents along the shore from Hurricane Erin
Now Playing3minBeach captains prep for challenging week amid Hurricane Erin, smaller lifeguard staff
Now Playing3minRip current warnings may close Bay Head beaches to swimmers
Now Playing9minSunny and breezy Tuesday in The Bronx; watch for dangerous rip currents
Now Playing3minHigh rip current risk in effect until at least Tuesday at the Jersey Shore
Now Playing3minCooler, breezy and mostly dry day in New Jersey
Now Playing3minSunny and cool Tuesday on Long Island; watch for dangerous rip currents
Now Playing2minTouch of autumn on Tuesday in the Hudson Valley
Now Playing3minSunshine returns this afternoon in Connecticut
Now Playing2minSunny and breezy Tuesday in Brooklyn; watch for dangerous rip currents
Now Playing3minSunny and fall-like Monday for Connecticut
Now Playing3minSunny and fall-like Monday for New Jersey
Now Playing3minFall-like Monday under breezy skies across Long Island
Now Playing2minFall-like Monday under breezy skies for the Hudson Valley
Now Playing2minFall-like Monday under breezy skies for Brooklyn
Now Playing2minFall-like Monday under breezy skies for The Bronx
Now Playing2minHot with a storm today in The Bronx, eyes on Hurricane Erin later this week
Now Playing3minHot with a storm today in Brooklyn, eyes on Hurricane Erin later this week
Sports
Now Playing3minFairfield National one win away from US Championship game
Now Playing2min18 Holes: Hole #13
Now Playing1minMan struck by lightning at Florham Park golf course
Now Playing2minGolfers hit the green at Bethpage Black one last time before the Ryder Cup
Now Playing3min'Super proud.' Fairfield National wins second game of Little League World Series over Hawaii 5-1
Now Playing3minUS Open Fan Week serves up tennis, star power and off-court fun
Now Playing1minStew Leonard Jr. honors late son with ceremonial first pitch at Yankees game
Now Playing1min'Why not us?' Trumbull Little League WS champ reflects on 1989 title run ahead of Fairfield National game
Now Playing1minWhite Plains soccer coach pleads guilty to kissing teen at youth clinic
Now Playing2min18 Holes: Hole #12
Now Playing1minApplications now open for 2026 FIFA World Cup volunteers
Now Playing1minStew Leonard Jr. prepares to throw first pitch at Yankees game
Now Playing1minMariano Rivera tears Achilles in Yankees Old-Timers' Day game and needs surgery
Now Playing2minSkaters revel in 'Tony Hawk Video Game Immersive Experience' at Peekskill skate park
Now Playing2min77th Yankees Old-Timers' Day celebrates the 2000 World Series championship team
Now Playing3minAbrupt end to Ferris World Ball league shocks players
Now Playing2min3 injured in shooting following basketball tournament in White Plains
Now Playing2minFormer Devils make appearance at Newark back-to-school giveaway
Now Playing2minFairfield team heading to Little League World Series after dominant championship performance
Now Playing2min3 Bronx residents recovering from shooting following White Plains basketball tournament
Now Playing2minFerris World Ball league discontinued following shooting at tournament in White Plains
Now Playing2minHackensack halts $40 million sports complex plan after years of delays
Now Playing1minNorwalk honors youth tennis nonprofit for 30 years of service
Now Playing1minHudson Valley Renegades kick off Hope Week with cancer care packages
Now Playing1minFairfield Little League falls to New York at regional tournament
Politics
Now Playing3minRed flags that ban swimming go up on NJ beaches as Hurricane Erin closes in
Now Playing3minBlumenthal blasts push to target Connecticut's school vaccine law
Now Playing3minGOP state lawmaker wants to be Fairfield's first selectman, petitions for special election
Now Playing1minNews 12 Exclusive: Rep. Ritchie Torres endorses Kathy Hochul for governor
Now Playing3minState Sen. Tony Hwang announces plans to run for Fairfield first selectman after petitioning for a special election
Now Playing2minRed flags going up at beaches as surf conditions worsen from Hurricane Erin
Now Playing1minState Sen. Tony Hwang announces run for Fairfield first selectman
Now Playing1minCT, NJ and NY join lawsuit against DOJ to stop immigration requirements on victim funds
Now Playing3minPatients blast 'insatiably greedy' insurance increases at Hartford hearing
Now Playing11minPower & Politics: One-on-One with EPA Administrator Lee Zeldin
Now Playing11minPower & Politics: Governor race hits home stretch
Now Playing11minPower & Politics: State Sen. Ryan Fazio enters 2026 gubernatorial race
Now Playing1minBridgeport ballot fraud suspect accused of violating court order by contact witnesses
Now Playing1minCourt dates set for Atlantic City mayor and wife on child endangerment charges
Now Playing3min1-on-1: EPA chief Lee Zeldin discusses time with Trump administration, EPA agenda in extensive interview
Now Playing2minNewburgh Ward 3 primary decided by 1 vote; candidate alleges election fraud
Now Playing1minState Sen. Ryan Fazio announces run for governor
Now Playing3minPrinceton officials urge state to pass Immigrant Trust Act in wake of ICE raids
Now Playing11minPower & Politics: 1:1 with John Ferretti - the Town of Hempstead's new town supervisor
Now Playing11minPower & Politics: Democratic Party's direction, Scarsdale girl freed from ICE custody, data from Westchester's school bus program p
Now Playing11minPower & Politics: The Race for NJ governor - new poll has Sherrill with 6-point lead over Ciattarelli
Now Playing11minPower & Politics: Gov. Lamont on impacts of GOP spending bill; 1:1 with CT health chief
Now Playing2minMonmouth County takes control of former Marlboro Psychiatric Hospital site
Now Playing3minThe Cost Of: Electric bill spike fuels political blame game in New Jersey
Now Playing1minState Sen. Ryan Fazio exploring run for governor
Crime
Now Playing2min2 gunmen linked to Crown Heights mass shooting remain at large
Now Playing3minTheft of beloved Newark restaurant owner's van caught on camera
Now Playing1minSuspect arrested following 3-hour standoff
Now Playing2minFamily of 15-year-old rape victim in Crotona Park East pleads for justice
Now Playing2minGang crackdown in Nassau nets 42 arrests
Now Playing1minBridgeton man charged after fight with police in Somerset County
Now Playing2min1 person hospitalized following stabbing near Spring Valley church
Now Playing1minWoman confronts intruder in Shelton home during daytime break-in
Now Playing1minSuffern man accused of DWI in crash that injured 73-year-old
Now Playing1minRockland County man indicted on kidnapping and assault charges
Now Playing2minBronx man arrested for leaving suspicious package in Times Square
Now Playing1min2 men impersonated Nassau workers, tried to buy $43K worth of computers
Now Playing2min31-year-old man fatally stabbed in Morrisania
Now Playing1minTeen punched, cellphone taken after exiting 4 train
Now Playing1min25-year-old man hospitalized in Flatbush shooting
Now Playing1minCT, NJ and NY join lawsuit against DOJ to stop immigration requirements on victim funds
Now Playing2minNYC expands NYPD's Quality-of-Life division
Now Playing2min5 suspected MS-13 gang members indicted in 2 Nassau County attacks
Now Playing1minCommunity gathers for vigil after Crown Heights mass shooting
Now Playing2minBullets fly outside of Claremont Deli in broad daylight
Now Playing3minMan sentenced to life in prison for killing Sayreville councilwoman
Now Playing2minWoman critically injured in Linden shooting; suspect dies by suicide
Now Playing2minSacred object stolen from a Bensonhurst church
Now Playing1min3 'armed and dangerous' men accused in Millville murder now in custody
Now Playing1minPolice respond to shooting in Linden
Community Engagement
Now Playing3minFairfield National one win away from US Championship game
Now Playing3minFairfield National one win away from US championship game at Little League World Series
Now Playing3minBack To School: Classroom setup is a family affair for Norwalk elementary school teacher
Now Playing2minBrooklyn Book Festival to return to borough next month
Now Playing2minFree NYPD boxing gym in Mount Hope aims to empower Bronx youth
Now Playing3minTraffic, safety and overcrowding force Babylon town to make popular summer spot resident-only
Now Playing2minSleepy Hollow holds Ecuadorian Culture Day celebration
Now Playing3minVictoria Soto Foundation holds book giveaway for teachers impacted by funding shortages
Now Playing3minBridgeport pays final respects to beloved school security guard who died by suicide
Now Playing3minIllegal smoke shop transforms into barbershop after city raid in Bedford Park
Now Playing2minHuntington thrift shop celebrates National Thrift Shop Day with handmade bracelets for hospice care
Now Playing2minRed Hook Pool set to reopen Sunday, after monthslong closure
Now Playing3minNorwalk officials condemn ICE activity near police department
Now Playing3minMain Street Connecticut: Previewing the Milford Oyster Fest
Now Playing3minPGA Tour Superstore to open in Norwalk
Now Playing3minHomes for the Brave invites public to take part in signature fundraiser Saturday at SHU
Now Playing1minAlex Jones' InfoWars to be sold again to pay $1 billion to Sandy Hook families
Now Playing1minUnited Jewish Organizations breaks ground on first social services headquarters in Williamsburg
Now Playing3min'Unbelievable.' Fairfield National wins first game of Little League World Series 1-0 over Texas
Now Playing3min'I identify as more than an alcoholic.' 9th annual addiction awareness vigil aims to save lives
Now Playing3minBed-Stuy tenants, including pregnant woman, left for 10+ days without power as sewage leaks into unit
Now Playing1min'Why not us?' Trumbull Little League WS champ reflects on 1989 title run ahead of Fairfield National game
Now Playing1minWant a lighthouse? Fairfield's Penfield Reef is now up for auction
Now Playing3minHead of the Harbor 'imminently' preparing lawsuit to force repairs to storm-damaged road and surrounding area one year later
Now Playing3minBridgeport Schools devise chaperone program to help kids facing longer walks get to school safely
Social Issues
Now Playing2min'We have seen rats fleeing.' Rat sightings reported to 311 down citywide
Now Playing1minCT, NJ and NY join lawsuit against DOJ to stop immigration requirements on victim funds
Now Playing2minWoman found dead in car on Cross County Parkway had fatal gunshot wounds
Now Playing1minStep Up for the Brave Challenge raises funding for nonprofit and awareness for veterans
Now Playing3minBridgeport pays final respects to beloved school security guard who died by suicide
Now Playing3minIllegal smoke shop transforms into barbershop after city raid in Bedford Park
Now Playing2minViolent road rage outside Pelham Parkway playground leaves parents shaken
Now Playing3minNorwalk officials condemn ICE activity near police department
Now Playing3min'This is scary stuff.' Immigrant advocates protest 'ICE overreach' in Stamford
Now Playing2minAffordable apartments open in Downtown Brooklyn, but some raise safety concerns
Now Playing1minStamford VA Clinic signs 1 year lease following uncertainty
Now Playing3minHomes for the Brave invites public to take part in signature fundraiser Saturday at SHU
Now Playing3min1-on-1: EPA chief Lee Zeldin discusses time with Trump administration, EPA agenda in extensive interview
Now Playing2minResidents seeing red after DOT greenlights safety plans in Windsor Terrace
Now Playing3minResidents: Drugs, homelessness, trash plague Clifford Place Step Street
Now Playing3min'I identify as more than an alcoholic.' 9th annual addiction awareness vigil aims to save lives
Now Playing3minPrinceton officials urge state to pass Immigrant Trust Act in wake of ICE raids
Now Playing1minJersey Proud: Volunteers help build 'Larry's House' for veterans
Now Playing1minMan arrested for derogatory slurs outside a Stamford mosque; CAIR-CT urges hate crime charges
Now Playing3min'We're fighting hard.' Veterans meet with state's top VA official about Stamford clinic's future
Now Playing3minAG James warns New Yorkers about fake Bad Bunny concert tickets
Now Playing2minTenants living at Red Hook Gardens rally outside management office to demand repairs
Now Playing2minTerror on wheels: Sheepshead Bay moms call for action as teens take over playground
Now Playing2min$24.8M Brooklyn Skate Garden sparks environmental concerns from critics
Now Playing1minHomeland Security: Man accused in deadly Lakewood collision had history of DUI
Transportation
Now Playing2minHudson Valley residents push for improvements on Route 133
Now Playing3minMTA hearings begin on proposed fare and toll hikes
Now Playing1minAsbury Park lowers speed limit on all city roads
Now Playing1minMan fatally struck by NJ Transit train in Cranford
Now Playing2minHackensack officials call for safety audit from NJ Transit following deaths
Now Playing2minMTA proposing fare hikes, toll increases and ticketing changes. How you can weigh in today
Now Playing1minAsbury Park reduces speed limits in parts of the city
Now Playing3minToll of Commuting: Inside look at NJ Transit's K-9 unit
Now Playing2minLeaders of 5 LIRR unions say strike could be on horizon
Now Playing1min2nd pedestrian fatally struck on New York State Thruway this week
Now Playing1minFormer Newark Liberty Gate A17 sign to be displayed at Flight 93 National Memorial
Now Playing1minHealth officials warn of possible measles exposure at Newark Liberty in July
Now Playing1minPolice ID bicyclist killed in Yorktown crash, say driver had right of way
Now Playing3minPedestrian struck and killed on New York State Thruway
Now Playing1minYorktown crash kills bicyclist, driver hospitalized
Now Playing2minResidents seeing red after DOT greenlights safety plans in Windsor Terrace
Now Playing1minHackensack woman killed by NJ Transit train identified
Now Playing2min14 injured when NJ Transit bus crashes into PSE&G truck in Newark
Now Playing2minNJ Transit bus, PSE&G truck collision in Newark injures 14
Now Playing1minCrash on Somerstown Road renews calls for road repairs in Ossining
Now Playing1minFAA wants to extend Newark flight cap through October 2026
Now Playing2min1 dead, 1 critically hurt in I-87 crash in Clarkstown
Now Playing2minNew Norwalk bus system aims for faster, simpler service
Now Playing2minToll of Commuting: What's driving auto insurance costs through the roof?
Now Playing2minFatal Bardonia crash closes northbound lanes of New York State Thruway
Health & Wellness
Now Playing3minRed flags that ban swimming go up on NJ beaches as Hurricane Erin closes in
Now Playing2minResidents displaced by Kingsbridge fire 5 months ago say some units remain unlivable, damaged
Now Playing3minBlumenthal blasts push to target Connecticut's school vaccine law
Now Playing1minHealth officials investigate case of malaria in Morris County
Now Playing1minRescuer speaks after saving child from Belmar rip currents and witnessing sister's death
Now Playing2minRed flags going up at beaches as surf conditions worsen from Hurricane Erin
Now Playing3minbe Well: How to protect your hair all summer long
Now Playing3minTips to ease college admission anxiety
Now Playing3minGarden Guide: Simple design tips to make your garden your own
Now Playing2minRefreshing snacks for when you need a summer break
Now Playing2minbe Well: Protecting your pet's ear health
Now Playing4minFashion and beauty essentials for your next trip
Now Playing3minHow to make the perfect blend for your smoothie
Now Playing3minFitness in 4: Effective pool workouts
Now Playing1minPossible malaria case under review in Morris County
Now Playing1min5 deaths, 108 confirmed cases of Legionnaire's disease in New York City
Now Playing3minHow to find the right college that feels like home
Now Playing2minbe Well: New orthopedic surgical techniques
Now Playing5minbe Well: Delicious foods with real, wholesome ingredients
Now Playing3minWays to bring fun into your daily work schedule
Now Playing3minFitness in 4: Moves to boost energy and strength
Now Playing1minBridgeport nonprofit CEO creates family fitness boot camp
Now Playing2minWest Nile virus cases continue to increase; infected mosquitoes discovered throughout the tri-state
Now Playing2minWest Nile virus cases continue to increase; infected mosquitoes discovered in CT and NY
Now Playing1minWest Nile virus detected in mosquitoes at Bridgeport's Beardsley Zoo and Seaside Park
Education & Schools
Now Playing3minBlumenthal blasts push to target Connecticut's school vaccine law
Now Playing3minTips to ease college admission anxiety
Now Playing3minNews 12 Westchester & News 12 Hudson Valley hold back-to-school celebration
Now Playing3minBack To School: Classroom setup is a family affair for Norwalk elementary school teacher
Now Playing3minHow to find the right college that feels like home
Now Playing2minNews 12 Long Island holds back-to-school celebration
Now Playing3minCost Of: Shopping for school supplies
Now Playing2minConnecticut Sales Tax Free week offers savings to shoppers
Now Playing3minVictoria Soto Foundation holds book giveaway for teachers impacted by funding shortages
Now Playing2minStudents put programming skills to the test at robotics competition at Yonkers PAL
Now Playing1minFormer Bridgeport man guilty of mailing violent threat to Yale
Now Playing2minTeens learn how to be true rock stars by building their own instruments at Guitar Camp
Now Playing1minConnecticut student loan reimbursement program reopens Friday
Now Playing1minBeloved Westport educator dies at 47 after decades of service
Now Playing2minNews 12 Brooklyn holds back-to-school celebration
Now Playing2minFormer Devils make appearance at Newark back-to-school giveaway
Now Playing1minRevolutionary War house to become museum in time for America's 250th birthday
Now Playing1min'Things changed.' Mahopac superintendent announces retirement weeks before school year
Now Playing1minNearly 15,000 tickets issued for passing school buses in Westchester
Now Playing2minDeadline arrives for NYC Public, Charter schools to submit plans on bell-to-bell ban
Now Playing1minRidgefield schools hit by ransomware attempt, network taken offline
Now Playing1minAnnual National Sports Broadcasting Camp held at Seton Hall
Now Playing2minSummer is winding down. Here's how to get your student on a better sleep schedule.
Now Playing2minYale graduate Slain in NYC midtown shooting
Now Playing1minOfficials: Morris County school bus driver charged for leaving child on bus
Consumer
Now Playing4minFashion and beauty essentials for your next trip
Now Playing2minMTA proposing fare hikes, toll increases and ticketing changes. How you can weigh in today
Now Playing3minCost Of: Shopping for school supplies
Now Playing2minConnecticut Sales Tax Free week offers savings to shoppers
Now Playing1minBoil water advisory partially lifted following Paterson water main break
Now Playing1minCentral Hudson rate hike approved under 3-year plan in New York
Now Playing3minDay 8: Water main repairs may take up to 4 more days in Paterson
Now Playing2minLong Island home prices reach record highs, leaving some buyers struggling
Now Playing1minJetBlue to add new flights to Fort Myers, Tampa from MacArthur Airport
Now Playing2minNYC Health and Hospitals promotes wellness fair before the school year
Now Playing1minConnecticut student loan reimbursement program reopens Friday
Now Playing2minRockland Pulmonary workers on strike for fair contract in West Nyack
Now Playing4minLow water pressure, boil water advisory continues in parts of Paterson and nearby towns
Now Playing2minRockland Pulmonary workers on strike amid contract negotiations
Now Playing2minFood costs up 25% since 2020. Tariffs could push prices even higher
Now Playing4minbe Well: Custom home building tips
Now Playing1minUSPS planning holiday shipping price hike
Now Playing1minNation's largest landlord agrees to stop using rent-setting algorithm
Now Playing1minConnecticut shoppers to save during Sales Tax-Free Week starting Sunday
Now Playing3min200K people under boil water advisory as crews isolate leak from Paterson water main break
Now Playing2min'Absolutely amazing.' Consumers rejoice as 'Sales Tax-Free' week returns Aug. 17
Now Playing1minCheck your mailbox: NJ ANCHOR benefit letters go out this week
Now Playing4minNew Beauty tests skin and hair products to feel and look your best
Now Playing1minSugar cookies sold in tri-state Target stores recalled for potential wood contamination
Now Playing3minHome equity loans: The money you need might be under your own roof
Lifestyle
Now Playing3minStony Point Chamber of Commerce looks to make businesses 'whole' from losses due to pipeline construction
Now Playing3minTheft of beloved Newark restaurant owner's van caught on camera
Now Playing3minNews 12 takes deep dive into deadly 2015 Legionnaires' outbreak in South Bronx following Harlem outbreak
Now Playing3minbe Well: How to protect your hair all summer long
Now Playing3minGarden Guide: Simple design tips to make your garden your own
Now Playing2minbe Well: Protecting your pet's ear health
Now Playing4minFashion and beauty essentials for your next trip
Now Playing3minFitness in 4: Effective pool workouts
Now Playing3minFairfield National one win away from US Championship game
Now Playing3minFitness in 4: Moves to boost energy and strength
Now Playing2minBrooklyn Book Festival to return to borough next month
Now Playing2minFree NYPD boxing gym in Mount Hope aims to empower Bronx youth
Now Playing2minConnecticut Sales Tax Free week offers savings to shoppers
Now Playing2minSleepy Hollow holds Ecuadorian Culture Day celebration
Now Playing2minWoodlawn church celebrates 26 years of Ghanaian culture
Now Playing2minRed Hook Pool reopens following months of repairs
Now Playing2minJewish Music and Arts Festival returns to Valhalla for its 49th year
Now Playing1minBridgeport nonprofit CEO creates family fitness boot camp
Now Playing1minHoboken Italian Festival returns for 99th year
Now Playing3minWine aficionados and music lovers revel at 14th annual Putnam County Wine and Music Fest
Now Playing2minConstruction finished on Klein Memorial Auditorium's first building addition in its history
Now Playing2minBojangles to open first NYC location in decades in East Flatbush
Now Playing3minGloucester Township mulls fines, jail time for parents of some teens who get arrested
Now Playing3minCollege ring recovered after 56 years in the Long Island Sound
Now Playing2minWhite Plains Road residents reeling over 'unsanitary' street conditions; demand action from district leaders
Traffic
Now Playing1minAsbury Park lowers speed limit on all city roads
Now Playing1minAsbury Park reduces speed limits in parts of the city
Now Playing3minWestchester road to get much-needed facelift after years of vehicle, tire damage complaints from drivers
Now Playing1min2nd pedestrian fatally struck on New York State Thruway this week
Now Playing3minPedestrian struck and killed on New York State Thruway
Now Playing2minNewark's Market Street closes for hours following cooking oil spill
Now Playing3minCTDOT projects mid-October opening of vital Stratford road shut down by sinkhole
Now Playing2min1 dead, 1 critically hurt in I-87 crash in Clarkstown
Now Playing2minFatal Bardonia crash closes northbound lanes of New York State Thruway
Now Playing1minMotorcyclist killed in Newark crash
Now Playing1min3-vehicle crash shuts down Robert Moses Causeway
Now Playing1minMotorcycle crash snarls Route 112 traffic in Port Jefferson Station
Now Playing1minCar crashes into utility pole in Amityville, temporarily knocks out power
Now Playing1minPedestrian hospitalized after being hit by car in Wilton
Now Playing2minLife imitates art: Burnell Boulevard in Norwalk to be made 2-way again
Now Playing1minTractor-trailer rolls off NJ Turnpike onto Route 1&9 in Newark
Now Playing1minDetours planned for Route 9W as construction starts
Now Playing2minTractor-trailer rolls off NJ Turnpike onto Route 1&9 Truck in Newark
Now Playing1minMetal debris from truck crash closes 2 northbound lanes of Route 1&9 Truck in Newark
Now Playing1minNorthbound Thruway lanes closed in New Paltz after tractor-trailer rollover
Now Playing1minPolice: 79-year-old e-bike rider fatally struck by car in North Long Beach
Now Playing2minHomeowner: City is ignoring calls about widening sinkhole in Throgs Neck
Now Playing1minVIDEO: Flames engulf pickup truck on New Jersey Turnpike in Kearny
Now Playing1minShark River Channel to be closed to boat traffic for Route 71 bridge repairs
Now Playing1minRoute 1 eastbound in Orange reopens after morning closure
Environment
Now Playing2minResidents displaced by Kingsbridge fire 5 months ago say some units remain unlivable, damaged
Now Playing3min'Trash revolution.' 311 complaints about rat sightings down citywide
Now Playing2minNormal water pressure returns since 11 days after Paterson water main break; boil water advisory remains for some
Now Playing1minBoil water advisory partially lifted following Paterson water main break
Now Playing1minSpotted lanternfly problem now so widespread reports no longer needed
Now Playing3min'Tremendous progress' made to curb rodent infestation in downtown Huntington
Now Playing3minDay 8: Water main repairs may take up to 4 more days in Paterson
Now Playing1minWater service returning to Paterson residents following main break
Now Playing1minActivists call on state leaders to pass Climate Superfund Act
Now Playing2minAllerton resident asks city for help with a 'problem pin oak' tree in her neighborhood
Now Playing2minSpotted lanternfly infestation spreads across Long Island
Now Playing2min3 people injured after tree falls on pedestrians and car in Teaneck
Now Playing1minInjured hawk rescued by firefighters in Danbury
Now Playing2minPaterson water main break highlights concerns about aging infrastructure
Now Playing3min1-on-1: EPA chief Lee Zeldin discusses time with Trump administration, EPA agenda in extensive interview
Now Playing3minDay 6 of water main break issues in Paterson, North Haledon, Haledon & Prospect Park
Now Playing3minSeaside Heights beaches to close earlier on rough surf days amid recent drowning
Now Playing4minLow water pressure, boil water advisory continues in parts of Paterson and nearby towns
Now Playing3minDrowning prompts after-hours beach closures in Seaside Heights
Now Playing3min200K people under boil water advisory as crews isolate leak from Paterson water main break
Now Playing2minDiscolored water flowing into Nissequogue River after contractor struck an underground spring in Smithtown
Now Playing2minState officials warn about the dangers of heat; hot weather protocol activated
Now Playing2minCrews isolate water main break impacting 200K people in Passaic County
Now Playing5minWater continues to rush out of broken pipe, leaving thousands without water service
Now Playing3minWater main break Day 4: Uncontrolled leak affecting service for Paterson, surrounding areas
Business
Now Playing3minStony Point Chamber of Commerce looks to make businesses 'whole' from losses due to pipeline construction
Now Playing3minMade in Connecticut: Hoo Doo Brown Barbeque
Now Playing1min67 Family Diner reopens in Seymour after flood damage
Now Playing2minBrotherhood Winery values memories made as the country's oldest continually operating winery
Now Playing3minBay Plaza creates jobs, opportunity and events in The Bronx
Now Playing1minTop Tomato closing after 35 years in Yonkers
Now Playing1minCentral Hudson to pay $5 million for Wappingers Falls gas explosion
Now Playing2minControversial cannabis dispensary in East Setauket ordered to temporarily close amid legal dispute
Now Playing3minPGA Tour Superstore to open in Norwalk
Now Playing2minRoad Trip Close to Home: Albatross brings luxury mini golf and bowling to Edison
Now Playing3minShoppers paradise: Take a look at this warehouse filled with everything in Stratford
Now Playing3minShoppers paradise: Take a look at this warehouse filled with everning in Stratford
Now Playing1minStew Leonard Jr. honors late son with ceremonial first pitch at Yankees game
Now Playing3minKatonah woman creates custom-made jewelry inspired by community through Magi NYC
Now Playing1minNation's largest landlord agrees to stop using rent-setting algorithm
Now Playing1minConnecticut shoppers to save during Sales Tax-Free Week starting Sunday
Now Playing3minMade in New Jersey: Jetty surf brand brings Jersey Shore spirit nationwide
Now Playing1minSmall business fair in Bridgeport aims for entrepreneurs to network and grow
Now Playing3minWestport rejected a luxury hotel and marina project. Now developers are planning hundreds of apartments
Now Playing5minMain Street Connecticut: Showcasing the top spots in Norwalk
Now Playing1minEnzo's La Piccola Cucina to close after nearly 42 years in Lawrenceville
Now Playing5minConversation Connecticut: Gaetano Marra, broker/owner of Better Homes and Garden Real Estate Gaetano
Now Playing2minRestaurant owners warn Bed-Stuy community of man randomly terrorizing businesses and residents
Now Playing3minMade in the Hudson Valley: Croton-on-Hudson staple The Blue Pig celebrates more than 20 years of making homemade ice cream
Now Playing2minMade on Long Island: Uncle Joey's Rainbow Explosion in Farmingdale
Food & Fun
Now Playing2minRefreshing snacks for when you need a summer break
Now Playing3minHow to make the perfect blend for your smoothie
Now Playing1min67 Family Diner reopens in Seymour after flood damage
Now Playing3minUS Open Fan Week serves up tennis, star power and off-court fun
Now Playing1minYoung chefs in Mount Vernon participate in cooking competition as part of Culinary Explorers Academy
Now Playing2minDown The Shore: Fishing on the Point Princess
Now Playing4minChick-fil-A opens first Rockland location with long lines and local donations
Now Playing3minMaking delicious with mocktails with Hal's New York Seltzer
Now Playing2minLloyd's Carrot Cake to close temporarily for renovations
Now Playing2minFood Truck Friday: Right Coast Taqueria
Now Playing2minCasa Cugine serves up specialty Italian sandwiches from TikTok star
Now Playing2minHighlands Clamfest celebrates 30 years of summer fun
Now Playing3min'The Pizza State.' CT's tasty new license plates are finally out - with an added bonus
Now Playing2minFood Truck Friday: Chiddy's Cheesesteaks
Now Playing3minFood Truck Friday: Long Island Shucking Truck
Now Playing3minTake your hot dog pick: Rawley's Drive-In vs. Super Duper Weenie
Now Playing5minCarson Kressley's smart, stylish tips for your next summer getaway
Now Playing2minbe Well: Mocktails that will keep your happy hour on the healthy side
Now Playing2minFood Truck Friday: Bori Bites
Now Playing2minGrounds Donut House offers sweet and savory treats in Throgs Neck
Now Playing4minbe Well: How to throw a planet-friendly dinner party
Now Playing2minFood Truck Friday: Vice Doughnuts and Coffee
Now Playing1minBridgeport church holds food and clothing giveaway
Now Playing1minFrank Pepe's Pizza celebrates 100th birthday
Now Playing3minFood Truck Friday: Zef's Pizza Firetruck
Entertainment
Now Playing1minBruce Springsteen exhibit takes center stage in Long Branch
Now Playing3minFairfield National one win away from US Championship game
Now Playing2minConstruction finished on Klein Memorial Auditorium's first building addition in its history
Now Playing2min'They're all like home shows.' Rob Thomas to perform in Bridgeport Saturday
Now Playing2minNunley's Carousel reopens on Museum Row
Now Playing1minFright Fest set to return to Six Flags Great Adventure starting Sept. 12
Now Playing6minAlec Baldwin to perform special 1-night theatrical event on Long Island
Now Playing2minFilming for new 'Friday the 13th' prequel series now underway in New Jersey
Now Playing1minStew Leonard Jr. prepares to throw first pitch at Yankees game
Now Playing5minJames Quattrochi on 'Tulsa King' and working with Sylvester Stallone
Now Playing5minBrooke Shields on raising the standard of pet care and wellness
Now Playing1minDJ Mister Cee Way: Late hip-hop legend honored in street co-naming ceremony
Now Playing2minBronx Summer Concert Series comes to Van Cortlandt Park
Now Playing5minRocco DiSpirito dishes on his new pop-up restaurant
Now Playing1minLiam Neeson surprises fans at Amenia drive-in
Now Playing2minMore New Jersey towns become 'film-ready communities' to welcome film industry
Now Playing4minbe Well: Mike Merrill talks about his role on Tyler Perry's 'Straw'
Now Playing2minFans revel in WWE SummerSlam at MetLife Stadium
Now Playing1minFans get chance to meet WWE Superstars ahead of SummerSlam at American Dream
Now Playing4minMain Street Connecticut: Previewing the Orange Firemen's Carnival
Now Playing2minRadio legend Dennis Malloy bids goodbye to New Jersey 101.5 WKXW FM
Now Playing1minNew Milford reopens Housatonic River access point that closed after drowning
Now Playing3minSummer Shorts Film Fest returns to New Paltz with 58 films
Now Playing1minWestchester tenor wins Catholic Music Award at Vatican
Now Playing1minTop waddler and crawler crowned in Wildwoods baby contest